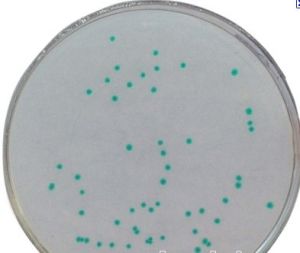
阪崎腸桿菌 阪崎腸桿菌

概述
阪崎腸桿菌阪崎腸桿菌(E.sakazakii)是人和動物腸道內寄生的一種革蘭陰性無芽孢桿菌,屬腸桿菌科腸桿菌屬,是腸道正常菌叢中的一種,在一定條件下可引起人和動物致病。在1980年之前一直被稱為黃色陰溝腸桿菌。隨著對該菌認識的加深,根據阪崎腸桿菌與陰溝腸桿菌DNA、RNA雜交、生化反應、色素產生和抗生素敏感性的不同,研究人員對該菌的分類提出了質疑。
發現過程
1961年,Franklin等首次報導了2例由阪崎腸桿菌引起的腦膜炎病例。以後相繼在世界範圍內(美國、冰島、荷蘭等國家)報導了一系列新生兒阪崎腸桿菌感染事件。
1976年Steigerwah等發現腸桿菌屬菌株可分為與“黃色素存在或缺失”相關的兩種不同的DNA雜交群。
1977年Brenner等發現可根據D一山梨醇產酸和延遲產生脫氧核糖核酸酶區分產色素和不產色素的菌株。
1980年Farmer等建議對產黃色素的陰溝腸桿菌重新分類,在同一篇文獻中Farmer等指出通過DNA—DNA雜交他們發現阪崎腸桿菌之間DNA一致性可達83%一89%,而阪崎腸桿菌與陰溝腸桿菌的DNA共有序列只有31%一49%。
阪崎腸桿菌能引起嚴重的新生兒腦膜炎、小腸結腸炎和菌血症,並且可引起神經系統後遺症和死亡,該菌感染引起的死亡率高達50%以上。截止2011年,雖然還不能確定阪崎腸桿菌的宿主和傳播模型,但在一些新生兒阪崎腸桿菌感染事件的調查中發現嬰兒配方粉是主要的感染渠道。
生物學性狀
培養特徵
阪崎腸桿菌阪崎腸桿菌兼性厭氧,營養要求不高,能在營養瓊脂、血平板、麥康凱(MacConkey,MAC)瓊脂、伊紅美藍瓊脂、脫氧膽酸瓊脂等多種培養基上生長繁殖。
所有的阪崎腸桿菌都能在胰蛋白酶大豆瓊脂上36℃快速生長,24小時後形成直徑2~3mm的菌落;25℃生長24h後形成直徑1~1.5mm的菌落,48小時後形成直徑2~3mm的菌落。Farmer等發現阪崎腸桿菌在結晶紫中性紅膽鹽葡萄糖瓊脂平板上首次劃線分離時,生長24小時後可生成2種或2種以上的菌落形態,一種乾燥或粘液樣,周邊呈放射狀,用接種環觸碰可發現菌落極富彈性;另一種是典型的光滑型菌落,極易被接種環移動。截止2009年,尚不清楚這兩種不同的菌落是否存在毒力和其它表型上的差別。Farmer等發現在TSA平板上培養24小時後,所有的阪崎腸桿菌都產生大量的沉澱物,像是包含團狀細胞和無定形組織。
生化反應
Muytjens等研究了阪崎腸桿菌和相關菌株的酶反應特點。在對229株(其中129株是阪崎腸桿菌)細菌的研究中發現阪崎腸桿菌和其它腸桿菌之間存在兩個主要的不同:阪崎腸桿菌a-葡萄糖苷酶活性均為陽性,其它腸桿菌均為陰性(包括產氣腸桿菌)、陰溝腸桿菌、成團腸桿菌;所有試驗菌株中只有阪崎腸桿菌缺少磷醯胺酶。
1985年Farmer等又檢測了57株阪崎腸桿菌,其中53株a-葡萄糖苷酶活性為陽性。由此認為,a-葡萄糖苷酶是用來快速區分阪崎腸桿菌和其它腸桿菌的可靠方法。1983年Aldova等評估了從捷克斯洛伐克分離的73株阪崎腸桿菌吐溫80脂酶的活性,結果顯示97.3%的菌株含有該酶。
1984年Postupa和Aldova研究了從奶粉和嬰兒配方粉中分離到的6株阪崎腸桿菌,發現所有的菌株在25℃和37℃培養7d後都產生吐溫80脂酶。大量的研究結果表明,阪崎腸桿菌的生化反應與陰溝腸桿菌相似。在鑑定阪崎腸桿菌時需注意,該菌總是氧化酶陰性、D一山梨醇陰性、產生吐溫80脂酶、細胞外DNAse陽性並形成黃色菌落。
抵抗力
Nazarowec-White等的早期研究認為嬰兒配方粉中阪崎腸桿菌的污染與該菌的高度耐熱性有關。然而,Breeuwer等研究發現阪崎腸桿菌並非具有特殊的耐熱性,但能耐受一定程度的滲透壓和乾燥。無論是Nazarowec.White等還是Breeu.wer等人的研究結果都證明,阪崎腸桿菌的耐熱性不足以使該菌經標準的巴斯德消毒後倖存,產品的污染很可能發生在乾燥和罐裝階段。與大腸埃希菌、沙門菌相比,阪崎腸桿菌對滲透壓和乾燥具有更高的耐受力,這很可能與細胞內大量的海藻糖酶有關。
Edelson.Mammel和Buchanan研究了人工污染阪崎腸桿菌(根據生產商推薦的沖調方法,配方粉稀釋液阪崎腸桿菌濃度約為106CFU/m1)的嬰兒配方粉長期存放時細菌的生存態。在將近一年半中配方粉室溫放置在一個密閉的帶蓋瓶子中,定期從中取樣做定量檢測,在最初的5個月內,阪崎腸桿菌活菌數量下降了2.5logCFU/ml(從6.0logCFU/ml下降到3.5logCFU/m1),每月約下降0.5logCFu/ml。隨後的1年內阪崎腸桿菌活菌數量又下降了0.5logCFU/ml,終濃度約3.0logCFU/ml。該結果證明阪崎腸桿菌能在嬰兒配方粉中長期存活。
增殖能力
阪崎腸桿菌的傳代時間在6℃,21℃,37℃分別是13.7h,1.7h,19~21min。對阪崎腸桿菌進行危險性評估發現,與本底相比,25℃放置6小時該菌的相對危險性可增加30倍;25℃放置10小時可增加30000倍。
因此,即使嬰兒配方粉中只有極微量的阪崎腸桿菌污染,在配方粉食用前的沖調期和儲藏期該菌也可能會大量繁殖。2004年2月FAO/WHO在日內瓦召開的嬰兒配方粉中阪崎腸桿菌專家研討會上提出嬰兒配方粉中微量的阪崎腸桿菌(<3CFU/100g)污染也能導致感染的發生。所以,對奶粉和嬰兒配方粉的加工製作過程、家庭、醫院的滅菌過程以及嬰兒配方粉的儲存和食用等關鍵控制點進行嚴格管理,是減少該類產品潛在危險性的重點。
毒力
國際上對阪崎腸桿菌的毒力因子和致病性知之甚少。Pagotto等在2003年首次描述了某些阪崎腸桿菌可能產生一種毒力因子一類腸毒素樣化合物。組織培養發現一些菌株可產生細胞毒效應。腹腔注射劑量達108CFU/只時,18株試驗株均可在3d內導致哺乳期小鼠死亡。經口灌胃,只有2株能引起哺乳期小鼠致死性損傷。SK92(腸毒素陽性)和MNW6(腸毒素陰性)腹腔注射致死劑量最小而在最大口服劑量時仍不能引起小鼠的致死性損傷。由此看來,阪崎腸桿菌之間的毒性存在明顯不同,而且,某些菌株可能是非致病性的,這在某種程度上可能與細菌在胃的酸性環境中存活能力有關。
生態分布
奶粉中的發現
阪崎腸桿菌嬰兒配方粉的污染在多起阪崎腸桿菌感染的調查研究中發現,阪崎腸桿菌腦膜炎和嬰兒配方粉緊密相關。
1988年,Muytjens等檢測了從35個國家收集的141種嬰兒配方粉,其中從13個國家的20種抽檢樣品中分離到阪崎腸桿菌(14.2%)。定量檢測結果顯示阪崎腸桿菌陽性樣品的污染水平很低,除5種樣品外,其他均低於1CFU/100g(0.36~0.92CFU/100g)。1983年Muytjens等從沖調好的配方奶中分離到阪崎腸桿菌,然而沒有從沖調用的水和配方粉中分離到該菌。1984年Postupa和Aldova從捷克斯洛伐克的配方粉中分離到2株阪崎腸桿菌。
1990年Clark等調查了2起不相關的院內暴發的新生兒阪崎腸桿菌感染事件。在每起暴發中,都同時從病人和嬰兒配方粉中分離到阪崎腸桿菌。採用多種分型方法(質粒分析、耐藥譜、染色體限制性核酸內切酶分析、核糖體分型和多位點酶切電泳)對各株阪崎腸桿菌的相關性進行分析後發現雖然各分型方法不同,但在同一暴發事件中,從病人和配方粉中分離到的阪崎腸桿菌具有相同的特徵。
2001年4月美國田納西州發生阪崎腸桿菌感染事件後,醫務人員與田納西州健康和疾病控制中心協同對感染源進行了調查。對同一新生兒重症監護室中49例其他嬰兒進行篩檢,結果從10例嬰兒體內分離到阪崎腸桿菌。為了查清感染源,研究人員對沖調配方粉的無菌水、已開罐的嬰兒配方粉、同一批次未開罐的嬰兒配方粉、用於沖調配方粉的用品等進行微生物學檢測。無菌水和沖調用品阪崎腸桿菌檢測為陰性,從未開罐和開罐的嬰兒配方粉中分離到的阪崎腸桿菌脈衝場凝膠電泳指紋圖譜與從腦膜炎患兒中分離到的相同。事件發生後,生產廠家在衛生部門的監督下收回了同一批次的所有產品,並對生產該批奶粉的工廠進行停產整頓。這是第一次因阪崎腸桿菌污染引起商業嬰兒配方粉被廣泛召回的報導。
2002年Block等報導了1999年12月至2000年月耶路撒冷一家醫院發生的一起早產兒硝酸鹽陰性阪崎腸桿菌感染事件。在這次感染中分離到的阪崎腸桿菌PFGE圖譜完全一致,但與1993年~1998年的分離株不同。該菌沒有從嬰兒配方粉中分離出來,但是從已沖調的配方奶和廚房的攪拌器中分離到。停止使用該攪拌器後,對其重複進行阪崎腸桿菌檢測發現至少5個月內仍可分離到陽性菌株,Block等因此認為攪拌器的阪崎腸桿菌污染可能來自該次感染事件發生之前使用的某批次的污染產品。更換使用另一廠家生產的嬰兒配方粉,並隔離已感染的患兒後,感染得到有效的控制。
2011年12月23日,美國密蘇里州2名嬰兒食用美國強生嬰幼兒配方奶粉後生病,其中一名嬰兒不幸死亡,知名連鎖商場沃爾瑪決定全面下架該款奶粉,美強生則稱奶粉出廠時未驗出細菌,無安全問題。嬰兒生病原因為感染阪崎腸桿菌。
環境分布
嬰兒配方粉在製造過程中要經過巴斯德消毒,阪崎腸桿菌經過這樣的處理後不可能繼續存活。因此,終產品中阪崎腸桿菌的污染很可能是來自廠房環境、巴斯德消毒後添加熱敏感性微量元素的過程或配方粉的沖調期。
對環境中阪崎腸桿菌的分布情況知之甚少。1990年Muyqens和Kollee為了解環境中阪崎腸桿菌的發生率,對其進行了廣泛調查,抽檢樣品包括地表水、土壤、泥漿、朽木、穀類、家畜、牛、生牛奶等,但未從抽檢的樣品中分離到阪崎腸桿菌。2002年Leclercq等從乳酪、碎牛肉、臘腸和蔬菜中分離到阪崎腸桿菌,但目前仍不能確定該菌的自然宿主。
2003年Hamilton等從廄螫蠅中腸中分離到阪崎腸桿菌,據此認為廄螫蠅幼蟲腸道是阪崎腸桿菌的環境宿主之一。廄螫蠅在世界範圍內廣泛分布,以牛、馬、狗、豬和人等的血液為食,在牛、豬或馬的養殖場所可見該蠅,在牛棚更常見,這使牛奶的污染成為可能。流行病學研究發現廄螫蠅的地理分布和阪崎腸桿菌感染直接相關。國際上已有從實驗室果蠅腸道內分離到阪崎腸桿菌的報導。美國一家疫情控制公司的技術報告中記載舍蠅中存在阪崎腸桿菌,但沒有確切記錄該菌究竟是在舍蠅體內還是體外。Hamilton等從以上報導推測昆蟲很可能是阪崎腸桿菌的環境宿主。該結論意味著,為了從根本上減少阪崎腸桿菌的污染,除了要在生產和產品使用期間實施各項控制措施外,還要在醫院和生產環境中加強對蠅的消殺工作。
2004年Kandhai等從9個工廠和16個家庭(餐桌)取樣147份進行阪崎腸桿菌的檢測,檢測結果顯示不同的環境檢出率各不相同,但差別無統計學意義。阪崎腸桿菌從奶粉、穀類、朱古力、馬鈴薯粉、意大利麵食加工廠和家庭環境中的檢出,為該菌在環境中的廣泛分布提供了強有力的證據。在設計預防新生兒阪崎腸桿菌感染的措施時,應該考慮到阪崎腸桿菌環境分布的廣泛性。
致病物質
1、阪崎腸桿菌的毒力因子和致病性現在(截止2012年)還不太清楚,但已發現有些阪崎腸桿菌可能產生一種毒力因子-類腸毒素樣化合物。而且,組織培養也發現一些菌株可產生細胞毒效應。
2、最近,TOWNSEND等發現嬰兒配方奶粉中含有細菌脂多糖——內毒素(LPS),具有熱穩定性,能增加小腸上皮細胞通透性,促使細菌侵入腸壁中而致病。
3、mange等通過體外組織細胞培養實驗觀察到阪崎腸桿菌對人類上皮細胞和腦微血管內皮細胞有吸附粘連特性,並形成叢生,表面形成生物保護膜。
4、由於阪崎腸桿菌細胞內含有大量的海藻糖酶,累積有大量的海藻糖,使得阪崎腸桿菌比沙門菌和其他腸桿菌更耐受滲透壓和乾燥。因阪崎腸桿菌這些特性,使得奶粉生產時不易殺滅,儲存時易生存下來。
致病性
阪崎腸桿菌感染的大多數病例都是嬰兒,特別是早產兒、出生體重偏低等身體狀況較差的新生兒。感染主要引起腦膜炎、膿血症、壞死性小腸結腸炎,阪崎腸桿菌引起的腦膜炎常引起腦梗塞、腦膿腫、囊腫形成和腦室炎等併發症,並且可引起神經系統後遺症或迅速死亡。除了感染新生兒外,該菌偶爾還可引起成人局部感染和菌血症等。
1、嬰幼兒腦膜炎:未足月出生的新生兒占75%。主要表現為發熱,面色蒼白,有抽搐或顫抖,張力亢進,囪門隆出,無頸項強直。合併有菌血症者占5/8,壞死性小腸結腸炎占2/8,死亡率高達75%。阪崎腸桿菌引起的腦膜炎常引起腦梗塞、腦膿腫、囊腫形成和腦室炎等併發症,並且可引起神經系統後遺症或迅速死亡。
2、新生兒菌血症:寒戰,白細胞偏低,血液培養分離可得到阪崎腸桿菌,多數症狀較輕,如出現嚴重的膿毒血症,死亡率可達36%
3、新生兒壞死性小腸結腸炎(NEC):多發生於未足月出生體重較輕的嬰幼兒。
4、成人感染:阪崎腸桿菌引起成人菌血症或局部感染。
檢查
1、不利用山梨醇。
2、36度下培養七天,DNA酶為陽性。
3、根據阪崎腸桿菌中寡-1,6-葡萄糖苷酶基因設計引物建立PCR方法,並進行PCR反應的靈敏度、特異性實驗以及模擬實際樣品的最低檢出限測定。
菌落特徵
在胰蛋白腖瓊脂(TSA)、腦心浸液瓊脂(BHI)及血平板上經25~36℃培養24h後,形成1.5~2.5mm,黃色菌落,菌落形態有2種:一種為典型的光滑型菌落,極易被接種環移動,另一種為乾燥或粘液樣,周邊呈放射狀,不易被接種環移動,似橡膠狀有彈性。後一種經傳代後可轉化為有光澤的菌落。
培養溫度
阪崎腸桿菌具有耐熱及耐寒性,在外界環境中比其他腸道桿菌生存率強,培養最佳溫度25—36℃,在6~45℃下都能生長,某些菌株可在47℃下生長。菌落顏色
阪崎腸桿菌在MAC瓊脂上為無色透明菌落,在TSA及BHI上生長為黃色菌落,在結晶紫中性紅膽鹽葡萄糖瓊脂(VRBG)能產生紫紅色菌落,而在TSA上加5-溴-4-氯-吲哚-α-D-吡喃葡萄苷(Xα-GLC)僅阪崎腸桿菌能產生蘭綠色菌落,現已作為阪崎腸桿菌快速培養的選擇性培養基,在4-甲基-傘形酮-α-D-葡萄糖苷(NA+α-MUG)培養基上產生螢光菌落。
抵抗力
耐高溫、乾燥、滲透壓
阪崎腸桿菌比其他腸桿菌耐高溫,LEHNER研究發現阪崎腸桿菌在嬰兒配方奶粉中60℃存活2.5min,並且72℃仍能存活。BREELLWER等觀察阪崎腸桿菌在58℃下能持續0.39~0.60min不死。由於阪崎腸桿菌細胞內含有大量的海藻糖酶,累積有大量的海藻糖,使得阪崎腸桿菌比沙門菌和其他腸桿菌更耐受滲透壓和乾燥。因阪崎腸桿菌這些特性,使得奶粉生產時不易被殺滅,儲存時易生存下來。
耐酸性
阪崎腸桿菌耐酸性並對清潔劑和殺菌劑有較強抵抗力。LEH—NER的實驗表明,阪崎腸桿菌能在pH0.9~2下存活(胃部的酸性環境),可能與阪崎腸桿菌周身菌毛結構有關,該菌毛結構易使細菌形成共生集合體,也易粘附在各種物體表面形成一層生物保護膜,對清潔劑和殺菌劑具有較強的抵抗力。
治療
1、一般說來,與腸桿菌屬其它細菌相比,阪崎腸桿菌對常用的抗菌藥更敏感。
2、阪崎腸桿菌對先鋒黴素1和新諾明之外的所有試驗用藥敏感,且該菌是唯一對氨比西林敏感的腸桿菌。
3、雖然阪崎腸桿菌的最佳抗生素治療方法尚未確定,但在大數早期報告的病例中都是套用氨比西林和慶大黴素聯合療法。
預防
1、嬰兒出生的前六個月,母乳餵養最有助於嬰兒的生長和健康。但是為了保證嬰兒發育需要的營養,必須科學地補充餵養適宜的母乳代用品,如符合食品法典委員會(CAC)標準的嬰兒配方食品。應對不能進行母乳餵養的嬰幼兒,特別是高危人群提出警示:配方乳粉並不是滅菌產品,可能被病原體污染並引起疾病。
2、用商業無菌液體或開水沖調配方食品,餵食嬰兒剩餘的液體調配食品應放置冰櫃保存,並在食用前再加熱。
控制方法
1、制定嬰幼兒配方奶粉中阪崎腸桿菌微生物標準,建立有效控制措施,將其危險性降低到最低。
2、制定加工、使用和操作嬰幼兒配方食品的導則,研究降低阪崎腸桿菌污染水平的方法,在生產環境和配方奶粉中降低阪崎腸桿菌的濃度和流行的危險性;為高危人群生產較大比例的商業無菌配方替代產品。
3、制定有效的環境監測計畫,將腸桿菌科而不是大腸桿菌作為工業生產線的衛生指標菌。
4、建立實驗室監測網路,對阪崎腸桿菌的來源、傳播途徑等進行調查研究;加強相關學科的基礎研究,包括生態學、分類學、菌株毒力等。
5、用商業無菌液體或開水沖調配方食品,餵養嬰幼兒後剩餘的調配食品應放置冰櫃保存,並在食用前再加熱。我國應根據實際情況制定相應管理辦法,加強對阪崎腸桿菌的檢測技術及控制技術研究,進一步完善嬰幼兒配方食品標準,以保證嬰幼兒群體的健康與安全。
生化反應
阪崎腸桿菌在定名前一直被伯傑分類為產黃色素的陰溝腸桿菌,實際上是陰溝腸桿菌的一個亞種,因此與陰溝腸桿菌的生化反應有許多相似的地方。阪崎腸桿菌與陰溝腸桿菌有31%~49%的DNA序列同源性,G+C含量為57%。
MUYTJENS等在對226株(其中129株為阪崎腸桿菌,其他為陰溝腸桿菌60株,產氣腸桿菌19株,聚團腸桿菌18株)腸桿菌的研究中,發現阪崎腸桿菌和其他腸桿菌之間存在兩個主要的不同:阪崎腸桿菌α-葡萄糖酶苷活性均陽性,而缺乏磷醯胺酶活性。由此認為,憑兩種酶活性檢測可將阪崎腸桿菌與其他腸桿菌明顯地區分開來,並且將α-葡萄糖酶苷活性檢測可用來快速分離阪崎腸桿菌。
POSTUPA研究了從嬰兒配方奶粉中分離到的6株阪崎腸桿菌,發現所有的菌株都能產生吐溫-80脂酶。因此,吐溫-80脂酶活性測定也可以作為阪崎腸桿菌的鑑定依據。
檢測必備儀器--螢光pcr儀
實時螢光定量PCR檢測系統也叫實時螢光定量核酸擴增檢測系統(英文全名是Real-timeQuantitativePCRDetectionSystem),簡稱實時螢光QPCR,qPCR的核心是實時螢光定量PCR儀及與其配套的檢測分析軟體系統。
聚合酶鏈式反應(PolymeraseChainReaction簡稱PCR)原理憑藉敏感、特異、快速的特點榮獲1993年諾貝爾化學獎。因其在病原體檢測方面的獨特優勢,因而已開發國家在相關方法和儀器方面的研發非常快,成為分子生物學診斷的主流,至今仍處於學術和套用前沿,發展至今已有三代產品:第一代PCR定性檢測技術及設備由基因擴增熱循環儀(DNAThermalCycler)+電泳儀+紫外分析儀+定性試劑構成;第二代PCR-DNA終點定量技術及設備(End-pointquantitativePCRdetection)由基因擴增熱循環儀+螢光儀+終點定量試劑構成,其又分為終點酶免定量(End-pointELISA-PCR)和終點螢光定量(End-pointFlour-PCR)兩種;第三代產品為Real-timeqPCR-DNA/RNA實時螢光定量檢測。
qPCR檢測靈敏度高,檢測線性範圍寬,檢測精度和重複性好等突出優勢,因此被公認為目前世界用於臨床及科研的最先進核酸分子診斷技術,被美國FDA承認並推崇。檢測項目包括:食物等病原菌以及疾病病毒等病原體如:B肝病毒HBVDNA,C肝病毒HCVRNA,愛滋病病毒HIVRNA,沙眼衣原體CT,淋病雙球菌NG,巨細胞病毒CMV,結核分支桿菌Mtb、禽流感、阪崎腸桿菌、口蹄疫、新城疫、豬瘟、大腸埃希菌O157∶H7、沙門菌、炭疽芽孢桿菌、胸膜肺炎放線桿菌、寄生蟲病等。
PCR儀的套用範圍廣,幾乎所有的生命科學領域都要涉及:食品檢測、臨床檢驗、疾病控制、檢驗檢疫、科研實驗室、食品安全、化妝品檢測、環境衛生等。國內多家試劑廠商生產了包括肝炎、性病、優生優育、呼吸道疾病、禽流感、阪崎腸桿菌、口蹄疫、新城疫、豬瘟、大腸埃希菌O157∶H7、沙門菌、炭疽芽孢桿菌、胸膜肺炎放線桿菌、寄生蟲病等在內的數十種螢光定量PCR試劑盒,購買方便,價格便宜,並獲得了國家相關認證。
近期動態
美國俄克拉荷馬州一名嬰兒被檢測出對阪崎腸桿菌(Cronobacter)呈陽性反應,此前該病菌已導致一名嬰兒死亡,另一名患病。美國目前正對嬰兒配方奶粉進行調查。
美國疾病防控中心發言人BarbaraReynolds周二表示,阪崎腸桿菌有時會導致新生兒罕見疾病,以前在嬰兒配方奶粉中曾發現該細菌。
俄克拉荷馬州衛生部的LesleaBennett-Webb稱,最新檢測出陽性反應的這名嬰兒還不到一個月大,未食用過美贊臣(MeadJohnsonNutrition)(MJN.N:行情)Enfamil嬰兒配方奶粉,入院治療後已出院。
這是近幾周發生的第三起阪崎腸桿菌病例,此前該病菌已導緻密蘇里州一名嬰兒死亡,伊利諾州一名嬰兒患病,目前正在康復中。美國食品藥物管理局稱,密蘇里州那名嬰兒曾食用Enfamil配方奶粉,而伊利諾州那名嬰兒曾食用Enfamil以及其它多種品牌配方奶粉。
沃爾瑪(WMT.N:行情)等美國零售商已將Enfamil奶粉下架,但目前聯邦調查人員尚未發現病例與該奶粉存在關聯。
2005年5月20日,由中國檢驗檢疫科學研究院和天津出入境檢驗檢疫局牽頭完成的《奶粉中阪崎腸桿菌檢測方法》行業標準在京通過了審定。這項標準的出台,解決了我國檢測嬰幼兒配方奶粉中阪崎腸桿菌無標準、無檢測方法的問題。10月該標準被實施。
該標準建立了阪崎腸桿菌的改進的傳統檢測方法、普通PCR方法和螢光PCR方法。
據了解,阪崎腸桿菌是乳製品中近幾年新發現的一種致病菌。它是存在自然環境中的一種“條件致病菌”,已被世界衛生組織和許多國家確定為引起嬰幼兒死亡的重要條件致病菌,可導致任何年齡層人群的疾病,尤其是對早產兒、出生體重輕的嬰兒或免疫受損嬰兒的威脅最大,嚴重者可導致敗血症、腦膜炎或壞死性小腸結腸炎。
繼美國FDA2002年在本土某一些國際乳業巨頭生產的嬰兒配方奶粉中檢出阪崎腸桿菌後,2003年又一家國際乳業巨頭公司主動召回在美國生產的一批檢出極微量阪崎腸桿菌的罐裝早產兒特殊配方奶粉,此後成為世界關注的焦點。我國在2005年5月通過《奶粉中阪崎腸桿菌檢測方法》行業標準的審定,對奶粉嚴查此菌。